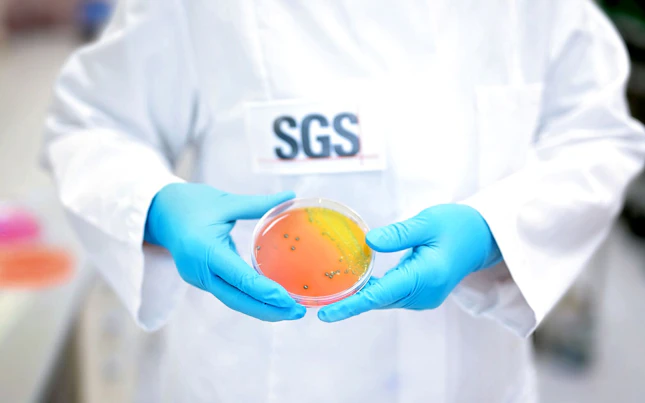

Lebensmittelsicherheit und -qualität sind von größter Bedeutung. Mikrobiologische Untersuchungen gewährleisten, dass die von uns verzehrten Lebensmittel frei von schädlichen Mikroorganismen - Bakterien, Viren, Schimmelpilzen, Hefen, Parasiten usw. - sind. - die lebensmittelbedingte Krankheiten verursachen. Durch strenge Tests werden diese Mikroorganismen nachgewiesen und quantifiziert. Sie liefert wichtige Informationen, die es Lebensmittelherstellern, Aufsichtsbehörden und Verbrauchern ermöglichen, fundierte Entscheidungen zu treffen und Risikominderungsstrategien anzuwenden, die Ausbrüche verhindern und die öffentliche Gesundheit schützen.

Umfassende Lösungen
Wir bieten das gesamte Spektrum an mikrobiologischen Lebensmitteltests an, die über ein weltweites Netz von hochmodernen Labors durchgeführt werden. Mit Hilfe der neuesten Methoden und Techniken erkennen und identifizieren unsere hochqualifizierten Experten die Mikroorganismen, die Lebensmittel verderben und die menschliche Gesundheit gefährden können. Wir decken ein breites Spektrum an Krankheitserregern ab, darunter Bakterien, Viren, Schimmelpilze, Hefen und Parasiten sowie andere Indikator- und Verderbsmikroorganismen.
Unsere Testverfahren können auf eine Vielzahl von Lebensmitteln angewendet werden - Frischwaren, Milchprodukte, Fleisch, Geflügel, Meeresfrüchte und verarbeitete Lebensmittel - und umfassen sowohl qualitative als auch quantitative Methoden. Durch fortschrittliche molekulare Techniken wie PCR und DNA-Sequenzierung können wir das Vorhandensein bzw. Nichtvorhandensein selbst der schwer fassbaren spezifischen Mikroorganismen feststellen, bevor wir ihre Konzentration in einer Probe messen.
Suchen Sie etwas Bestimmtes?
Suche innerhalb von Lebensmittel-Mikrobiologie